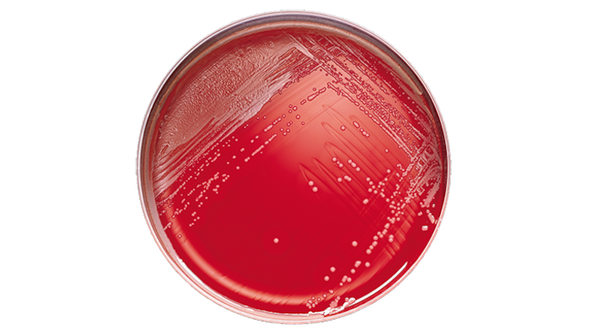
BD BBL Phenylethyl Alcohol Agar Plate with 5% Sheep Blood – Selective Medium, 84-Day Shelf Life

Description
BD BBL CDC Anaerobe 5% Sheep Blood Agar with Kanamycin and Vancomycin Plate is designed for laboratories that require reliable anaerobic culture media. This product supports accurate microbial identification and helps streamline workflow in clinical and research settings. Ideal for microbiology labs processing a high volume of anaerobic samples, each plate is formulated for consistent results and ease of use.
- 100 Plates Per Pack – Reduces restocking frequency, keeps your lab running smoothly.
- 70-Day Shelf Life – Supports efficient inventory management, helps maintain confidence in supply.
- Prepared Culture Media – Ready to use for immediate testing, saves valuable technician time.
- Diagnostic Accuracy – Formulated for reliable results, supports peace of mind in daily testing.
Anaerobic Culture Media for Reliable Microbial Testing
This prepared culture media is developed for laboratories needing consistent performance in anaerobic bacterial identification. The inclusion of kanamycin and vancomycin supports selective growth, while the 5% sheep blood agar base enhances detection of clinically relevant organisms. Designed for busy clinical and research labs, this product helps reduce preparation time and supports accurate diagnostic workflows. The 100-plate pack size is ideal for high-throughput environments, and the 70-day shelf life allows for flexible inventory planning. Using this media, lab professionals can focus on delivering timely and reliable results for patient care and research projects.
Features and Benefits
Optimized for Anaerobic Cultures
- Selective Antibiotic Supplementation – Contains kanamycin and vancomycin to support targeted microbial growth.
- 5% Sheep Blood Agar Base – Enhances detection of clinically significant anaerobes.
Convenient Laboratory Workflow
- Pre-Poured Plates – Ready for immediate use, reduces hands-on preparation time.
- Bulk Packaging – 100 plates per pack for efficient supply management in busy labs.
Quality and Consistency
- Standardized Formulation – Ensures reproducible results across batches.
- Diagnostic Efficiency – Supports accurate and timely microbial identification.
Product Specifications
General Information
- Category: Prepared culture media
- Pack Size: 100 plates/pack
- Shelf Life: 70 days
Identification and Traceability
- SKU: 221736
- GTIN (Each): 00382902217367
- GTIN (Bag): 10382902217364
- GTIN (Shelfpack): 30382902217368
Explore More: See all Prepared Culture Media | Shop more BD BBL Products
Consistent Results and Efficient Lab Operations
Choose this prepared culture media for streamlined lab processes and reliable microbial testing. The bulk pack and extended shelf life help your team stay focused on results, not supply issues. Designed for accuracy and ease, this product supports confidence in every test run.
- Bulk Packaging Advantage – 100 plates per pack reduces ordering frequency and supports uninterrupted workflow.
- Reliable Shelf Life – 70-day shelf life offers flexibility for inventory planning and reduces waste.
- Selective Media Formulation – Kanamycin and vancomycin support targeted growth for accurate identification.
- Trusted Brand – Manufactured by BD BBL, a recognized leader in laboratory media solutions.
Frequently Asked Questions (FAQs)
What is the shelf life of this prepared culture media?
The shelf life is 70 days, allowing for efficient inventory management in the lab.
How many plates are included in each pack?
Each pack contains 100 plates, suitable for high-throughput laboratory environments.
What antibiotics are included in the media?
This media contains kanamycin and vancomycin to support selective growth of anaerobic bacteria.
What is the base of the agar in these plates?
The base is 5% sheep blood agar, which enhances detection of clinically significant organisms.
Is this product ready to use upon arrival?
Yes, the plates are pre-poured and ready for immediate use in laboratory testing.
What is the SKU for ordering this product?
The SKU for this product is 221736.
Which brand manufactures this prepared culture media?
This product is manufactured by BD BBL, a trusted name in laboratory media.